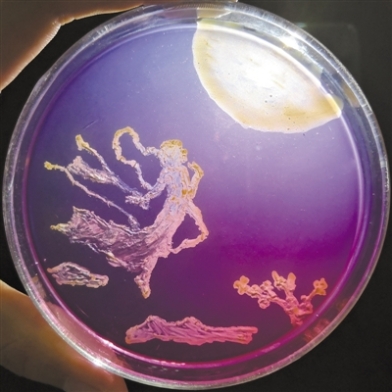
3 3
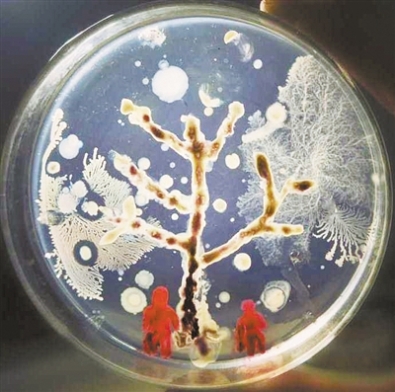
9 9

提到微生物,你第一時(shí)間會(huì)想起什么?是致人死亡的疾病,還是有益于腸道健康的菌群?在科學(xué)家的眼中,微生物有了另一個(gè)用途:“畫畫”的好材料。
受訪者供圖
色彩絢麗的嫦娥奔月圖、季節(jié)變換春夏秋冬四季景色……近日,沈陽藥科大學(xué)生命科學(xué)與制藥學(xué)院的學(xué)生們?cè)诶蠋煹闹笇?dǎo)下,以培養(yǎng)皿做畫布,微生物做“顏料”,完成了一幅幅精美的藝術(shù)作品——其實(shí),這些絢麗的色彩,是微生物自己“長”出來的。
別小看了這小小的微生物畫作,它鏈接起了科學(xué)研究鏈條的兩端,既能培養(yǎng)學(xué)生對(duì)學(xué)習(xí)本專業(yè)的興趣,也可以在高大上的論文中扮演重要角色。
不同菌種產(chǎn)生不同顏色
直徑9厘米的培養(yǎng)皿、按照流程消毒后的實(shí)驗(yàn)器材、稀釋后的土壤標(biāo)本……準(zhǔn)備好這些材料,可以開始繪制一幅“畫作”了。近日,沈陽藥科大學(xué)生命科學(xué)與生物制藥學(xué)院上演了一幕別開生面的畫展:利用微生物作畫。
受訪者供圖
在培養(yǎng)皿里,各種不同的菌株搖曳多姿,或是散落滿地的潔白冰花,或呈現(xiàn)一片春花盛開的景色,或者是模仿秋天落葉的一片金黃;除了景色,九色鹿、蒙娜麗莎甚至校園的大門……紅色的紅球菌,黃色的黃桿菌,橙色的橙色單胞菌,白色的芽孢桿菌,有綠色絨毛的青霉菌,還有能產(chǎn)生各種顏色色素的鏈霉菌等等微生物,將它們的藝術(shù)之美演繹得淋漓盡致。
該校負(fù)責(zé)此次比賽的穆老師介紹,微生物作畫的原理其實(shí)就是菌種的培養(yǎng),從自然環(huán)境中找到合適的菌種,根據(jù)它們自身不同的顏色,利用無菌操作等方式,讓菌種長成一幅漂亮的畫。
菌株想要長成一幅畫,最大的難點(diǎn)是對(duì)“顏料”的提純。一旦混入了其他細(xì)菌或者純化程度不足,就無法取得預(yù)料之中的色彩。想要解決這個(gè)問題,就必須按照科學(xué)研究的規(guī)律和實(shí)驗(yàn)規(guī)范來進(jìn)行操作。
“實(shí)驗(yàn)室中各個(gè)步驟的無菌操作是對(duì)同學(xué)們的第一大要求。”沈陽藥科大學(xué)生命科學(xué)與制藥學(xué)院副院長、教授張怡軒介紹說,而參加本次畫展的每一位同學(xué),都嚴(yán)格遵守了實(shí)驗(yàn)要求:首先,實(shí)驗(yàn)中使用的培養(yǎng)皿、竹簽等都要先經(jīng)121℃高溫高壓濕熱滅菌30分鐘才能使用;其次,操作前要先將工作臺(tái)空間中的微生物紫外照射30分鐘殺滅,操作過程中也要避免微生物的侵入;最后,工作臺(tái)上一直要吹動(dòng)過濾過的無菌風(fēng),同時(shí)燃著酒精燈形成無菌區(qū)域。在此三重?zé)o菌保障下,一幅幅美麗的作品才能誕生。
從指導(dǎo)學(xué)生學(xué)習(xí)操作規(guī)范到挑選菌種、純化培養(yǎng),再到一個(gè)個(gè)帶有顏色的斑點(diǎn)慢慢成長,最終長成一幅色彩斑斕的作品,前后共花費(fèi)了一個(gè)多月的時(shí)間?!翱粗暌稽c(diǎn)點(diǎn)長大,最后按照我們的想法長成一幅畫,這種感覺特別奇妙,充滿了樂趣,”參賽選手、沈陽藥科大學(xué)生物工程專業(yè)本科生王爽說。
小細(xì)菌背后的大學(xué)問
細(xì)菌分為很多種類,如何選擇有用的細(xì)菌,并對(duì)其進(jìn)行處理,是整個(gè)微生物研究環(huán)節(jié)的第一步。以這次畫展為例,繪畫使用的“原材料”也就是細(xì)菌,主要來源于原始森林植物根部的土壤和部分中藥材,許多菌種都是學(xué)生們暑假期間到大別山考察時(shí)帶回來的。
從大別山采集回來后,他們采用梯度稀釋涂布法,將藥用植物靈芝、天麻、西洋參等中藥材的根際土壤進(jìn)行處理;接下來通過三區(qū)劃線法等方式進(jìn)行純化擴(kuò)大,將每一種“顏料”單獨(dú)挑出、層層分離、純化、擴(kuò)大,如此再三,才能得到各種單一顏色的“顏料”。
那么,這些作品的圖案是怎樣形成的呢?
細(xì)菌雖然個(gè)體微小,但生長總是比較規(guī)矩,菌種接種在哪里它就生長在哪里,給它一道線條它就長成一條道路,給它一片區(qū)域它就長成一座山峰;而真菌個(gè)體相對(duì)較大,它的孢子能夠到處飄揚(yáng)而不可控,落在這里形成一朵,落在那里形成一片。于是,菌種一般被用來勾勒出線條,而真菌孢子則形成錦簇的花團(tuán),或者波濤洶涌的云海。
學(xué)會(huì)收集、分離和處理菌株
對(duì)于親手制作微生物作品的同學(xué)們來說,這次比賽還有著更深層次的意義?!拔覀兊某踔韵M寣W(xué)生們學(xué)到更多知識(shí),對(duì)科學(xué)研究產(chǎn)生興趣,更可以讓他們了解到科學(xué)研究究竟是如何進(jìn)行的?!睆堚幷f。
張怡軒介紹,收集、分離和處理菌株,本身就是該學(xué)院的一項(xiàng)重要工作。因?yàn)閷W(xué)院建設(shè)有沈陽藥科大學(xué)藥用物質(zhì)資源庫——微生物資源中心,主持了國家自然基金項(xiàng)目、科技部“自然科技資源平臺(tái)—藥用微生物資源中心”建設(shè)子課題,所保存的各類微生物菌種已達(dá)1萬余株,共鑒定為280余屬,1240余種。菌種來源于土壤、水體、洞穴、藥用植物內(nèi)生、腸道及各種極端環(huán)境,用于科學(xué)研究。
張怡軒告訴科技日?qǐng)?bào)記者,微生物資源中心成立以來,已經(jīng)取得了多項(xiàng)重大成果,維生素C生產(chǎn)菌就是其中之一。
我國維生素C發(fā)酵工業(yè)年產(chǎn)在16萬噸以上,占世界總產(chǎn)能的90%,是國內(nèi)醫(yī)藥領(lǐng)域的支柱性產(chǎn)業(yè)之一,更是遼寧省制藥業(yè)輝煌時(shí)代的象征之一。依托于微生物資源庫,張怡軒率領(lǐng)團(tuán)隊(duì)對(duì)維生素生產(chǎn)流程中的關(guān)鍵步驟進(jìn)行優(yōu)化,升級(jí)了傳統(tǒng)方法中微生物菌種,完成了混菌體系的全基因組測(cè)序、蛋白質(zhì)組學(xué)分析及在發(fā)酵不同階段下的轉(zhuǎn)錄組分析,明確了混菌體系中一系列生理活性物質(zhì)在菌株互作、代謝物交互過程中的作用及機(jī)制。新的工藝節(jié)約企業(yè)年運(yùn)行成本1000萬元以上。
通過進(jìn)一步研究,張怡軒團(tuán)隊(duì)還利用微生物資源中心從土壤中分離出不需要大菌伴生即可獨(dú)立生長產(chǎn)酸的小菌SPU_B003,并通過菌株體內(nèi)碳代謝流改造及系列關(guān)鍵功能基因的敲除、補(bǔ)充及增強(qiáng)等手段,對(duì)候選菌株發(fā)酵能力進(jìn)行增強(qiáng),有望提升二步發(fā)酵效率,降低生產(chǎn)成本,從而創(chuàng)造可觀的效益。
“對(duì)菌種的篩選,其實(shí)就是微生物資源中心這些科研活動(dòng)的一部分,通過這次畫展,學(xué)生們既可以學(xué)到知識(shí),對(duì)微生物學(xué)科產(chǎn)生興趣,同時(shí)還能參與到深層次的科學(xué)研究中來,讓學(xué)生們擁有很強(qiáng)的參與感,如果其中有人因此而愿意投身科研事業(yè),更是一舉多得?!睆堚幷f。(科技日?qǐng)?bào) 記者楊侖)